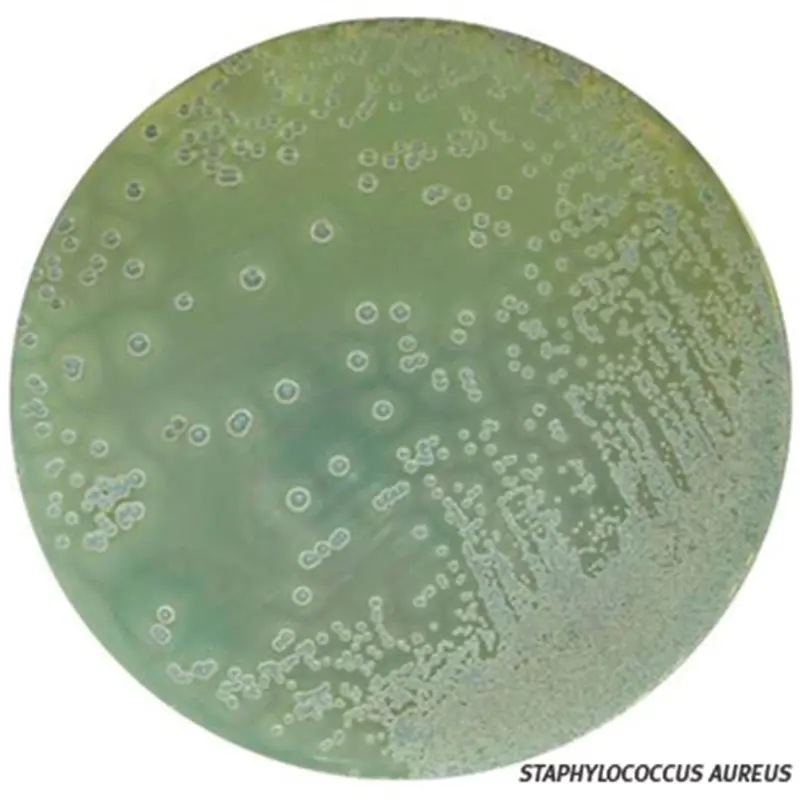

Unité de vente : 10
Marque : ClearLine
Référence fabricant : 693396
Code NACRES : NA.74
Connaître la disponibilité ?Connectez-vous
33,40 €

Vous allez être redirigé vers l'interface de votre navigateur dédiée à l'impression et à l'enregistrement en PDF.
Sélectionnez l'option qui vous convient dans le menu déroulant "Destination".
Suppléments (pour 100 ml de milieu)• Jaune d'oeuf au tellurite : 5 ml
• Sulfaméthazine à 0,2 % : 2,5 ml
RPF Supplément (ISO-FDIS 6888-2)• Fibrinogène bovin : 380 mg
• Plasma de lapin : 2,5 ml
• Trypsine : 2,5 mg
• Tellurite de potassium : 2,5 mg
• Incubation méthode traditionnelle (jaune d'oeuf +sulfaméthazine) 37 °C pendant 24 - 48 h
• Incubation méthode ISO-FDIS 6888-2 : 37 °C pendant 18 - 24 h